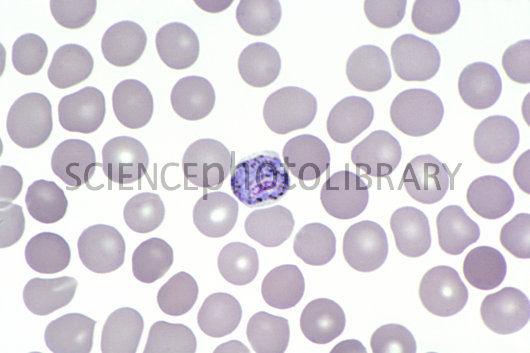

What is the significance of normal flora and their role in diseases of their host? Discuss.
They provide a surface that is incompatible for attachment of an invader, they establish competition for nutrients and vitamins, they produce antimicrobial substances, and they stimulate the immune system.
How could the use of a medium that is both selective and differential be justified?
Provides nutrients and environmental conditions that favor certain microbes and not others.
Define
a. Selective medium b. Differential medium
-Designed to stop the growth of certain bacteria and encourage the
growth of other desired microbes.
-Allows two or more organisms
to be distinguished from one another by a certain characteristic, like
growth vs. non-growth.
State the usefulness of MSA medium and EMB agar.
− MSA: if the bacteria ferments mannitol the phenol red indicator
turns yellow
− EMB: differentiates between lactose and non
lactose fermenters
E.coli and Enterobacter are both gram-negative rods that look similar under the microscope. What tests would you perform to differentiate them?
Indol
Methyl Red,
Voges-Proskauer
Citrate
Staphylococcus epidermis and Staphylococcus aureus are both Gram-positive cocci in clusters that look similar under the microscope. What test would you perform to differentiate them?
Coagulase test
Indicate the specific selective and/or differential purpose of MacConkey agar.
Used to isolate and differentiate members of the Enterobacteriacae based on the ability to ferment lactose
Explain the purpose of crystal violet in MacConkey agar medium.
Inhibits the growth of gram-positive bacteria
What is the substrate in the catalase reaction? Is it positive or negative when bubbles are formed? Why are bubbles produced?
− Hydrogen peroxide catalase
− Positive
− Because catalase
is an enzyme of aerobes and facultative anaerobes that converts H2O2
to H2O and O2 gas
Write four sentences on plasmids
composed of DNA or RNA
double-stranded or single-stranded
linear or circular
they may produce antibiotics (toxins) that help the host to compete for food or space
How is mutation different from horizontal gene transfer?
Mutation is a change in nucleotide sequence in a single gene whereas horizontal gene transfer involves the transfer of many genes to a cell.
Why is it necessary to constantly research and produce new antibiotics?
Antimicrobial
Because organisms may become resistant to antibiotics if used often.
Why is the disk-diffusion method not a perfect measure of how an antibiotic agent performs in vivo (in a living patient)?
Antimicrobial
Because in the disk method it is placed directly on the tested substance which is not the case in the living patient
Why is determining the sensitivity of a microorganism to antimicrobial substances important?
Antimicrobial
So that we can see how effective it is and also to see if a new antibiotic is needed or perhaps that they need to change something about the existing antibiotic.
Why should antibiotics not be given for viral infections?
Antimicrobial
Antibiotics kill bacteria but they cannot kill viral infections so it would just be aiding the body in becoming resistant to that antibiotic.
How would you have to modify this procedure to test antibiotic sensitivity of an obligate anaerobe?
Antimicrobial
You would have to alter the procedure in order to have a successful experiment when involving an obligate anaerobe. Alteration would have to be made to accompany the different type of organism and you would have to be careful and pay close attention.
Indicate the specific selective and/or differential purpose of MacConkey agar.
− Used to isolate and differentiate members of the Enterobacteriacae based on the ability to ferment lactose.
What is the significance of normal flora and their role in diseases of their host? Discuss.
-May keep pathogen numbers under control by competiting with them for nutrients, producing harmful substances, altering environmental conditions so they cant live
Why is it important to distinguish streptococcus pneumoniae from other streptococci?
So you know what to treat
What is the procedure to identify bacteria cultured from a boil on the patient's neck?
A boil is usually the result of a staphylococcal or a streptoccal infection. First cultured in a broth medium, followed by streak plate inoculations on blood and mannitol agar. If S.aureus a yellow halo will be present surrounding colonies in Mannitol and Beta hemolysis evident in blood agar. If pathogenic streptococcus, beta hemolysis on blood agar and no growth on mannitol plate.
How could the use of a medium which is both selective and differential be justified
used for isolation and differentiation between the Enterobacteriaciae
How could a test that should be done to diagnose rheumatic fever be explained?
Rapid antigen for strep
How would you explain the purpose of blood in blood agar medium
Will change color if the bacterium is able to produce protens that lyse the RBC.
Would a person living in the tropics or in the desert have larger numbers of bacteria living on the surface of their skin?
The very low humidity of the desert would lead to rapid evaporation of sweat and sebum from an individual's skin. Bacteria need these secretions for a nutrient source. Without them, bacteria would be found in much lower numbers on the skin of a person in the desert than the skin of the person in the tropics.
Why is it not surprising that staphylococci are the leading cause of wound infections?
Easily transmitted because its common on skin and nostrils
Why do many tetanus victims fail to respond to tetanus antitoxin?
It only neutralizes the unbound toxin
Give the virulence factors for the following diseases: scarlet fever and diphtheria.
Scarlet- Mprotein, hemolysin, streptolysin,
hyaluronidase
Diphtheria-toxin prevents polypeptide synthesis,
cell death
Name the plasmodium species that causes anemia.
Merozoites
How does the immune system protect us from disease?
The immune system includes physical barriers, such as the skin that prevent pathogens from entering the body, and cellular responses, that respond to foreign invaders.
Why is rapid detection of disease exposure important?
For many diseases, detecting the infection and beginning treatment early may reduce the severity of the symptoms or even prevent the disease completely. Rapid detection of disease exposure is also important to prevent further spread of the disease
Why are enzymes used in ELISA assay?
Enzymes provide a way to see whether or not the primary antibody has attached to its antigen.
Why do you need to assay positive and negative control samples as well as your experimental samples?
Controls are needed to make sure the experiment worked so we don't get any false positives or negatives.
Why did you need to wash the wells after each step?
Washing removes any proteins that have not bound to the plastic wells and any antibodies that have not bound to their targets, thus preventing unbound proteins (either antigen or antibodies) from giving false positive results.
When you added primary antibody to the wells, what happened if your sample contained the antigen? What if it did not contain the antigen?
If the sample contained the antigen, the primary antibody bound the
antigen
If the sample did not contain the antigen, the primary
antibody did not bind and wash flushed out in the wash step.
When you added secondary antibody to the wells, what happened if your sample contained the antigen? What if it did not contain the antigen?
If the sample contained the antigen, the secondary antibody bound to the primary antibodies already bound to the antigen in the wells.
If the sample gave a negative result for the disease-causing agent, does this mean that you do not have the disease? What reasons could there be for a negative result when you actually do have the disease?
A negative result does not mean that you do not have the disease. It could be a false negative. The ELISA may not be sensitive enough to detect very low levels of the disease agent, as might occur if one is tested soon after infection before a proper immune response occurs. Another cause of false negatives is experimental error, such as putting a negative control in a well where you thought you were putting an experimental sample
If you tested positive for disease exposure, did you have direct contact with one of the original infected students? If not, what conclusions can you reach about transmissibility of disease in a population?
Having intimate contact with another person means that you are exposed to any germs that a person may have contracted from any previous intimate contact
Sporangium:
sac like structures that hold the immature sporangiospores
Sporangiophore
arm like structure that holds sporangium and can help produce sporangiospores
Sporangiospore
asexual spores that will form new sporangiophores
What is meant by dimorphism?
Fungi can change from a unicellular yeast form to a multicellular mold form
Why are yeast classified as fungi and how are they different from fungi?
They are classified as fungi because are unicellular like many other kinds of fungi, they are different in how they have sporangium and sporangiophores.
Name two diseases caused by mold in humans. Include the causative organism, symptoms, and treatments.
Valley Fever: caused by C. immitis, causing flu like symptoms like
fever, cough, and chest pain. Treatment include medications like
amphotericin
Sperlunkers disease: caused by H. capsulatum,
causing fever, cough, and chest pain. Treatments include itraconazole
What other techniques might you use to identify organisms once you determine the morphological, cultural, and physiological characteristics?
Genetic, antimicrobial resistance and immunological tests
How are molds both beneficial and harmful? Explain.
Beneficial-pest control, hep b vaccine
Harmful- spoilage on
fruits, grans and vegetables
Why is it important to pasteurize fruit juice?
Kills pathogenic microbes
Are protozoa an important part of the food chain? Explain why.
Ingesting large numbers of bacteria and algae
How would increased travel lead to increased spread of multicellular parasites?
Many eukaryotic parasites depend on vectors for transmission so moving an infected individual into an area with new vectors and new susceptible humans would increase the spread of the illness
Nematoda- Ascaris lumbricoides

Protozoa- Entoemba histolytica

Protozoa-plasmodium
Platyhelthminthes taenia proglottid

Platyhelthminthes taenia ova

What conditions cause bacteria to grow
Warm temperatures
Moisture
Oxygen
Ph
Salmonella typi
typhoid fever
Myobacterium tuberculosis
Tuberculosis
Hemophilus Influenza
Bacterial meningitis
What causes tetanus
clostrydium tetani
Plasmodium falciparium
Vector is anopheles mosquito (female mosquito)
causes more virulant malaria